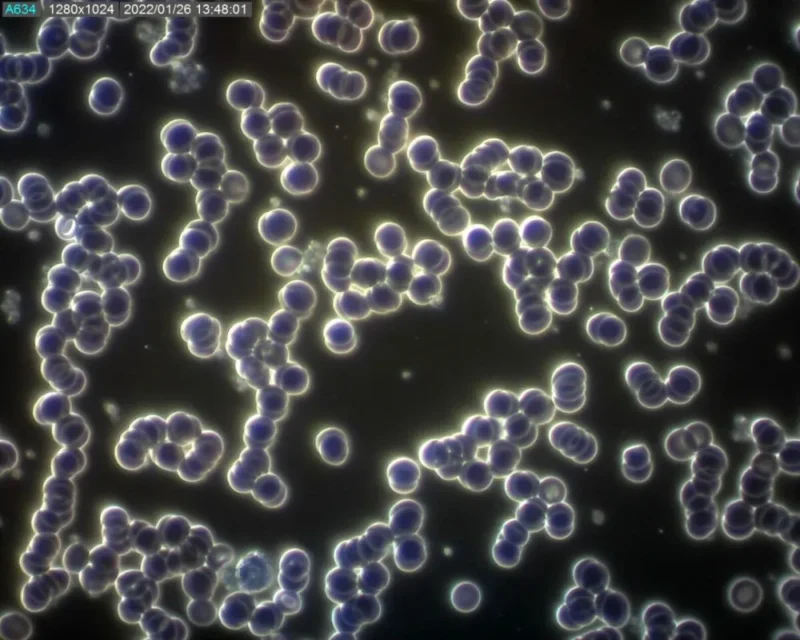
Kapka krve objevené alergie na lepek, laktózu nebo mléčnou bílkovinu

Vaše krev a neobjevená alergie na potraviny
Podívejte se, co s vaší krví může udělat neobjevená alergie na různé druhy potravin

Nejčastější alergie na lepek, laktózu nebo mléčnou bílkovinu
Naši poradnu navštívila paní, která měla dlouhodobé trávicí potíže, ztuhlost kloubů na ruce. Bohužel vše se řešilo občas injekcemi na bolest. My jsme našli příčinu!
Mnoho lidí v dnešní době trpí trávicími potížemi a většinou se to vše řeší léky na podporu trávení, pálení žáhy a podobně. Možná se pacientovi na čas uleví, ale příčinu to nevyřeší. Pokud střevo reaguje na alergen dlouhodobě, začne se oslabovat jeho funkce a dojde i k propustnosti střeva. Začne ve velké míře tyto alergeny vylučovat do krve. Vytvoří se velmi toxické prostředí a bohužel začne ovlivňovat kvalitu naší krve a tím i náš zdravotní stav.
Záleží na míře nesnášenlivosti nebo alergie. Cítíme se unaveni, ale časem máme stále větší problémy. Často se to projeví i na kůži – různé formy ekzémů a nemalá část klientů trpí právě nadměrnou ztuhlostí kloubů, bolestmi hlavy.
Pozorování kapky krve je úžasná preventivní metoda, která nám odhalí, co se v té krvi děje, respektive co je vaším střevem vylučováno zpět do krve a nepatří tam.
Na obrázku je krevní plazma plná toxických látek, střevo je velmi oslabené. Tělo je tím velmi překyselené, plné toxických látek. Červené krvinky (kuličky na obrázku) jsou shluklé, ztrácí energii.

Klientka na doporučení vysadila ze stravy mléko. Během 13 dnů úplně zmizela bolest ruky a cítí se úžasně. Důkazem je její opakované pozorování kapky krve.
Plazma skoro vyčištěná, toxiny se nově netvoří. Sliznice střeva se regeneruje a zesiluje.
Jen tak málo stačí. Hledat a najít příčinu. A to nás baví!
Pozorujte s námi živou kapku krve. Odhalte tajemství krve. Bezbolestná prevence zdraví.